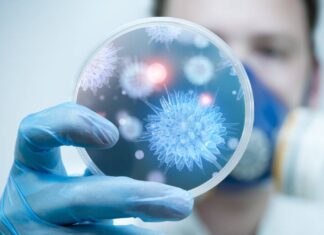
La física cuántica colabora en la lucha contra las infecciones y el cáncer
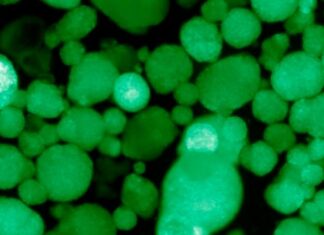
Crean las primeras células humanas trasplantables que producen insulina para tratar diabetes tipo 1

Invita COVEICYDET a participar en sus concursos “Mexicanas de Ciencia”
Xalapa, Ver., 18 Sept-20 (VRed).- El Gobierno del Estado, a través del Consejo Veracruzano de Investigación Científica y Desarrollo Tecnológico (COVEICYDET), en colaboración con...
La segunda temporada de ‘The Mandalorian’ ya tiene fecha de estreno
Ciudad de México., 3 Sept-20 (Agencia).- Disney Plus confirmó que la segunda temporada de The Mandalorian se estrenará el próximo 30 de octubre. Siguiendo el formato de la...
Franceses identifican las rocas espaciales que trajeron el agua a la...
(Agencia / 3 Sept-20).- Equipo de científicos franceses dio un paso para solucionar este añejo acertijo tras el anuncio en una publicación en la...
El tiempo existe y no existe en un túnel cuántico
(Agencia / 3 Sept-20).- En nuestro mundo, si golpeamos una pelota con un pie a la entrada de un túnel, podemos calcular cuándo saldrá...
La física cuántica colabora en la lucha contra las infecciones y...
Estados Unidos., 3 Sept-20 (Agencia).- Científicos de la Clínica Cleveland y de la Universidad Case Western Reserve de Estados Unidos han unido los esfuerzos...
Temperatura del último periodo glacial era seis grados más baja que...
Arizona, EUA., 26 Ago-20 (Agencia).- La temperatura promedio del último periodo glacial, aproximadamente hace 20 mil años, era seis grados centígrados más baja que hoy, frente a los 14 grados de media...
Allanado el camino para el Internet cuántico: logran su compatibilidad con...
Japón, 22 Ago-20 (Agencia).- Mediante una nueva técnica para el desarrollo de entrelazamientos cuánticos, que ya ha sido probada con éxito en distancias de...
Una supernova provocó una extinción masiva en la Tierra hace 359...
Illinois, EUA., 22 Ago-20 (Agencia).- Un estudio de la Universidad de Illinois ha llegado a la conclusión de que eventos astronómicos provocados por una...
Crean las primeras células humanas trasplantables que producen insulina para tratar...
EUA, 22 Ago-20 (Agencia).- Los científicos del Instituto Salk, en Estados Unidos, han logrado un gran avance en la búsqueda de un tratamiento seguro...
Científicos crean un robot del tamaño de un escarabajo movido por...
California, EUA., 22 Ago-20 (Agencia).- Los científicos imaginan que enjambres de insectos robóticos podrían ayudar en las operaciones de búsqueda y rescate . Pero...